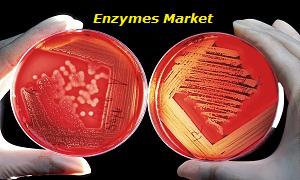

Press release
Enzymes Market is projected to expand at a steady CAGR over the forecast period 2025; Enzymatics (A Subsidiary of QIAGEN), Agilent Technologies, Amano Enzymes Inc., Bioline (A Subsidiary of Meridian Bioscience, Inc.), AB Enzymes, BioVision Inc., ENMEX, DN
Global Info Reports render to you profound details in respect to leading participants, regions, application and type of the Enzymes Market which is estimated to encounter substantial growth over the forecast period 2018-2025.Global Info Reports predict that the Enzymes Market size will escalate during the forecasted period while growing at a substantial CAGR. The report studies the market status and forecast and also categorizes the market into various segments. The report aims on the key market players in every region from across the globe.
Industry Updates:
Being updated with the emergent Enzymes Market and their latest trends gives companies the much-needed competitive advantage. Global Info Reports syndicated research reports acknowledges clients with different market objectives along with competitor profiling to Mergers & Acquisitions.
Top Prominent Players:
Enzymatics (A Subsidiary of QIAGEN)
Agilent Technologies
Amano Enzymes Inc.
Bioline (A Subsidiary of Meridian Bioscience, Inc.)
AB Enzymes
BioVision Inc.
ENMEX
DNA Polymerase Technology, Inc.
Biorbyt Ltd
DowDuPont Inc.
Sample Copy of this report is available here @ https://www.globalinforeports.com/request-sample/1070765
The Enzymes Market is segmented as follows-
By Product Type:
DNA Ligase
Restriction Enzymes
DNA Polymerase
Reverse Transcriptase
Other
By Application:
Biofuel Production
Animal Feed
Cleaning Products
Research and Biotechnology
Diagnostics
Food and Beverage
Other Application
By Region:
North America
Europe
Asia-Pacific
South America
Middle East and Africa
Ask Questions to Expertise at @ https://www.globalinforeports.com/send-an-enquiry/1070765
Major Table of Contents:
1.Executive Summary
1.Market Overview
2.Market Segmentation
3.Market Dynamics
2.Enzymes Market, By Product Type
1.Introduction
2.Global Enzymes Sales, Revenue and Market Share by Product Type
3.Global Enzymes Sales and Sales Share by Product Type
4.Global Enzymes Revenue and Revenue Share by Product Type
5.DNA Ligase
6.Restriction Enzymes
7.DNA Polymerase
8.Reverse Transcriptase
9.Other
3.Enzymes Market, By Application
1.Introduction
2.Global Enzymes Sales, Revenue and Market Share by Application
3.Global Enzymes Sales and Sales Share by Application
4.Global Enzymes Revenue and Revenue Share by Application
5.Biofuel Production
6.Animal Feed
7.Cleaning Products
8.Research and Biotechnology
9.Diagnostics
10.Food and Beverage
11.Other Application
To be continued…
Key Driving Factors of Market:
The major drivers, restraints, opportunities, challenges, and industry trends and their impact on the Enzymes Market forecast are discussed thoroughly.
Detailed profiles of various key companies are covered in the report along with their business overview, strategic development and financial data.
The developing factors of the market are discussed in-depth and different segments of the market are explained in detail.
The market report based on our unique research methodology delivers thorough analytical scrutiny of the Global Enzymes Market dispersed across several segments. The report also consists of current size and summary of the market of this industry coupled with outlook prospects. Moreover, key market manufacturers of Enzymes are studied on many aspects such as company overview, product portfolio, revenue details during the forecasted year. Also, the complete potential of the market is briefed in the full report.
Custom Report:
It’s a known fact that market research is a multifarious discipline wherein the demands and needs might differ in line with tactical needs of any business organization. Global Info Reports delivers custom research services to cater to the clients’ needs. With the present research abilities and proficient team of research consultants, Global Info Reports is furnished to any particular research requirements of businesses. The dedicated team of industry experts focuses on precise research activities to ensure that the clients get the correct people to fulfill their requirement.
Get Discount on Report at @ https://www.globalinforeports.com/check-discount/1070765
About Us:
Global Info Reports is a pioneer in off-the-rack market research. We study markets across the globe to assist our clients to analyze competitive activity and perceive further than market disruptions, and eventually grow intellectual business strategies. We offer vast portfolio of research reports with respect to geographical coverage, topics, and profiled companies. Global Info Reports has an experienced and skilled team which is dedicated to top-notch analysis and research. Our research team comprehends the demands of its clients and therefore keeps updating the reports as the market requirement changes. Our in-house professionals are highly motivated towards their work and meet the clients’ demands and deadlines irrespective of any time zone, thereby impeccably delivering projects.
Contact Us:
Call: +1-888-248-7621
Email: sales@globalinforeports.com
539 West Commerce, Suite #499, Dallas TX 75208, United States
This release was published on openPR.
Permanent link to this press release:
Copy
Please set a link in the press area of your homepage to this press release on openPR. openPR disclaims liability for any content contained in this release.
You can edit or delete your press release Enzymes Market is projected to expand at a steady CAGR over the forecast period 2025; Enzymatics (A Subsidiary of QIAGEN), Agilent Technologies, Amano Enzymes Inc., Bioline (A Subsidiary of Meridian Bioscience, Inc.), AB Enzymes, BioVision Inc., ENMEX, DN here
News-ID: 1432357 • Views: …
More Releases from Global Info Reports
Container As A Service (CaaS) Market 2020 Strong Development By Key Players, Res …
Latest Global Container As A Service (CaaS) Market research report is an in-depth study of the industry including basic structures. This report features market revenue, share, development and market size. Also accentuate Container As A Service (CaaS) industry contribution, product picture and provision. It examines a competitive summary of worldwide market forecast between period 2020 to 2025.
The Global Container As A Service (CaaS) market report gives information covering market competition,…
High Speed Diesel Engines Market Future Scope (2020-2025): Witness A Pronounce G …
An exhaustive investigation of this worldwide High Speed Diesel Engines market report 2020-2025 was distributed inside this examination, comprehensive of things like the business size concerning compensation and volume. High Speed Diesel Engines report clarifies in a precise assessment of the current state of High Speed Diesel Engines industry together with subtleties of the division.
The report presents definitions: the worldwide High Speed Diesel Engines market basics, applications, categories, and market…
Courier Services: Market 2019 Business Statistics Focus Report Growth by Top Key …
A detailed analysis of the Courier Services Market 2019 Industry research report has been compiled in this research study, inclusive of prominent factors such as the market size with respect to volume and remuneration. Also, Courier Services Market study elucidates in extensive detail the generic industry segmentation as well as a reliable evaluation of the current status of the market. The competitive scope of this business arena as well as…
BYOD (Bring Your Own Device): Market 2019 Global Analysis By Top Key Players – …
A detailed analysis of the BYOD (Bring Your Own Device) Market 2019 Industry research report has been compiled in this research study, inclusive of prominent factors such as the market size with respect to volume and remuneration. Also, BYOD (Bring Your Own Device) Market study elucidates in extensive detail the generic industry segmentation as well as a reliable evaluation of the current status of the market. The competitive scope of…
More Releases for Enzymes
Cake Enzymes Market Is Booming Worldwide | AB Enzymes, Advanced Enzymes, Maps En …
Advance Market Analytics published a new research publication on "Cake Enzymes Market Insights, to 2028" with 232 pages and enriched with self-explained Tables and charts in presentable format. In the Study you will find new evolving Trends, Drivers, Restraints, Opportunities generated by targeting market associated stakeholders. The growth of the Cake Enzymes market was mainly driven by the increasing R&D spending across the world. Some of the key players profiled…
Clean Label Enzymes Market | AB Enzymes GmbH, Advanced Enzymes Technologies, Ama …
The global clean label enzymes market report is a comprehensive report that provides a detailed analysis of the current status and future trends of the clean label enzymes market worldwide. This report provides valuable information to industry stakeholders by offering an in-depth perspective on market dynamics, competitive landscape, growth opportunities, and key challenges faced by industry participants.
From the perspective of market dynamics, this report explores the factors driving the growth…
Protein Hydrolysis Enzymes Market Business Strategies with Top Key Players Analy …
Global Protein Hydrolysis Enzymes Market Research report is an in-depth study of the market Analysis. Along with the most recent patterns and figures that uncovers a wide examination of the market offer. This report provides exhaustive coverage on geographical segmentation, latest demand scope, growth rate analysis with industry revenue and CAGR status. While emphasizing the key driving and restraining forces for this market, the report also offers a complete study…
Protein Hydrolysis Enzymes Market size, Share, Trends, Business Strategy to 2026 …
The Global Protein Hydrolysis Enzymes Market research report provides and in-depth analysis on industry- and economy-wide database for business management that could potentially offer development and profitability for players in this market. It offers critical information pertaining to the current and future growth of the market. It focuses on technologies, volume, and materials in, and in-depth analysis of the market. The study has a section dedicated for profiling key companies…
Bakery Enzymes Market || Key Player - Amano Enzymes, Advanced Enzymes, Novozymes …
A new report titled “Bakery Enzymes Market Growth Prospects and Industry Trends Analyzed till 2028” has been included in the enormous research repository of Market Research Reports Search Engine (MRRSE) that compiles various facets of the Bakery Enzymes Market at a global level portraying a holistic analysis of the marketplace along with intelligence on key participants. The report covers an unbiased analysis on various market aspects, emphasizing major trends giving…
Alkaline Proteases Market - Ab Enzymes, Acumedia Manufacturers, Inc., Advanced E …
Advancements in molecular biology has greatly reshaped the pharmaceutical and biotechnology industry over the last couple of decades. Rapid innovations in healthcare technology has also boosted growth of pharmaceuticals verticals, including alkaline proteases market scenario.
Enzymes have long been used as alternatives to chemicals to improve the efficiency and cost-effectiveness of a wide range of industrial systems and processes. Alkaline proteases also known as basic proteases are a group of enzymes…